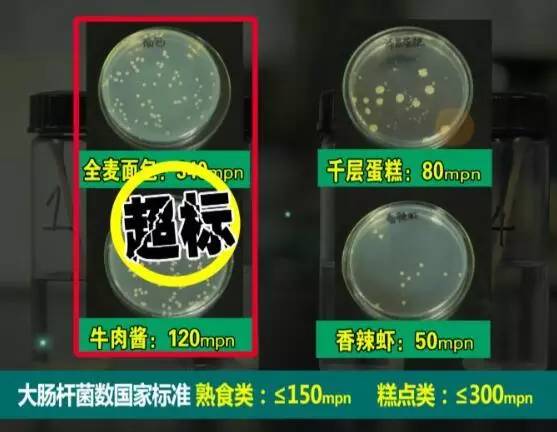
朋友圈卖化妆品微商被骗囤货,微信朋友圈买旅游产品被骗

只要你转发集赞,就可以免费送手机、免费送名牌口红香水、免费送香浓咖啡......这样的转发信息,在你的朋友圈里是不是很常见?测测你在古代会是谁、手机号码测吉凶、算算你五年后开什么车......这样的朋友圈小游戏是不是让你玩的不亦乐乎?当心啦,这些有可能都是“套路”,骗你没商量!
集赞送礼靠谱吗?

当你集赞的数量达到商家的要求后,可能真的会收到礼品或者返券,只不过很有可能是货不对版、或者是根本无法真正使用的返券。这种行为就是“零负团费”的翻版,很可能被强迫消费!

天价运费!

货不对版!
此外,还有商家需要用户自己出邮费,就是“免费送品牌商品,到付高额运费”!往往三四元的劣质商品,挂上了免费赠送的名头后,运费需要十几二十元,消费者得不偿失!

【提醒】
一般最好选择本地相关活动参加,举办方应当是认证的官方公众号且有实体店。如果在集赞送礼活动中遇到陷阱,记得保留参加活动的截图,然后向工商部门投诉,追讨权益!
玩测试小游戏会泄漏个人信息吗?

类似此类微信测试游戏是有后台服务器的。其后台本来只能得到用户的微信号,但只要你在测试中填写了自己的真实姓名,你的姓名就会与微信号在数据库中关联起来,这样你的微信号、姓名、生日等私密信息就被完全暴露。

如有不法分子倒卖这些信息,你就有可能受到大量骚扰短信;不法分子还会利用*取盗**的信息冒充本人向朋友进行诈骗、获取其网银、支付宝等金融支付工具。

【提醒】
微信朋友圈里面还有算命、情商测试、星座运势等也会引导你输入自己的个人信息。在社交网站中遇到此类“测试”时,不要点击进行操作,不要输入个人的真实信息。不同软件或网址注册时,也要尽量设置为不同密码,防止不法分子收集隐私信息。
“一件代发”月入过万?产品质量难保障

一件代发,就是转发商家的图片,只要有朋友愿意买,哪怕只有一件,商家都可以免费发货,你就可以赚取中间的代理提成了。

赚钱真的只用轻松动动手指就好么?

【提醒】一件代发有风险!
(1)看不到商品,商品质量无保证,售后风险你得承担。
(2)初期高额加盟费,小心血本无归。有些一件代发的公司需要加盟费,完不成销售任务,钱是不退的,入市需谨慎。
(3)当心遇到只收代理费的皮包公司。
一件代发的货源无法保障,东西卖出去之后,售后无法保障,时间一长,在朋友圈失去信任,东西就卖不出去了。
朋友圈售卖自制食品,真的健康无添加吗?
自制香辣的凤爪、美味的蛋糕……随着微商圈的扩大,售卖的东西也多得令人目不暇接。其中,不少打着“纯天然”、“纯手工”、“无添加自制”等旗号的食品,在朋友圈中受到青睐。这些食品真的如同宣传图片里那样美好吗?

检测数据表明,这些“无添加”、手工自制的食品,并没有想象中的那么美好!另外,食物的存储、运输也是问题,如果密封、存储温度不当,食品很容易发生变质!!!


【在朋友圈卖自制食品要*证办**才行】国家食药监总局日前发布的《网络食品经营监督管理办法(征求意见稿)》明确,网上经营土特产应取得食品经营许可或备案凭证,网络食品交易第三方平台如不能提供经营者具体信息须担责。
【律师提醒】
微信仅仅只是一个交流平台,并不负责商品销售和监管,一旦在交易过程中出现问题,消费者很难维权。

还有这些情况需要注意啦!
遇到微信好友索要电话号码和验证码时,应该引起注意,最好打电话向好友确认求证!
遇到朋友圈“众筹捐款”转发时,应该在捐款前查看注册用户的真实信息,并选择大型、正规众筹网站发布的信息进行爱心捐款。
不要轻易相信朋友圈里的微信、明星代言截图,网上的截图生成软件可以生成任何对话,明星代言产品图片也可以PS,一定要当心啦!
如果有微信群要求缴纳会费、拉下线等行为,应该引起注意,马上退群,以免陷入传销或类传销陷阱!!!



更多朋友圈陷阱大揭秘!!!
今晚22:00湖北卫视《金装生活·帮》
主编/滨哥
编辑/王一
节目信息:《金装生活·帮》
播出时间:每周三22:00